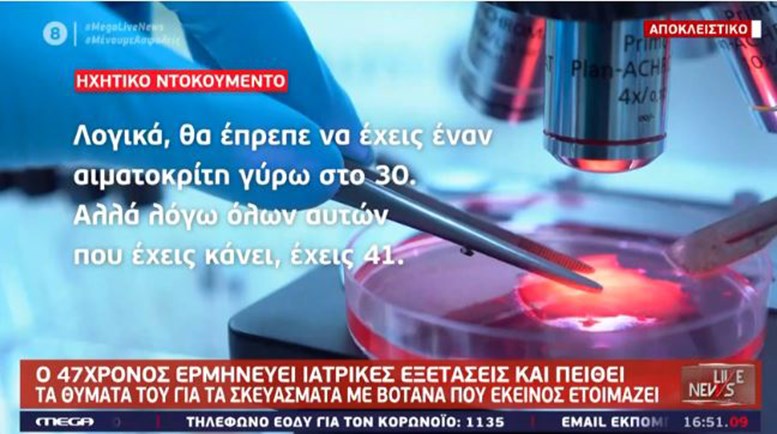
“Μαϊμού” γιατρός: Διάλογοι σοκ με καρκινοπαθή – Νέο ηχητικό ντοκουμέντο – ΒΙΝΤΕΟ

Μορφή χιονοστιβάδας παίρνουν οι αποκαλύψεις για τη δράση του “μαϊμού” γιατρού με το Mega να παρουσιάζει το απόγευμα της Παρασκευής νέο ηχητικό ντοκουμέντο από τη δράση του.
Συγκεκριμένα, ο 47χρονος ψευτογιατρός το πάει ένα βήμα παρακάτω μετά το χθεσινό ντοκουμέντο, όπου ανέλυε τις… επιπτώσεις του οξυγόνου, ώστε να πούμε… bye bye στον καρκίνο. «Ο καρκίνος είναι αναερόβιος. Όταν του δώσουμε εμείς οξυγόνο, τέλος πέθανε. Για αυτό τον λόγο, εάν καταφέρεις και του δώσεις πάλι οξυγόνο και νερό και πάει στο 71% δεν είναι καρκινικό. Αυτό σημαίνει ότι ο καρκίνος bye bye» ακούγεται να λέει ο 47χρονος.
Αυτή φορά, λοιπόν, Αναλύει τις εξετάσεις ενός καρκινοπαθούς, επιχειρεί να αποπροσανατολίσει και να μπερδέψει το θύμα του, με τις δήθεν εξειδικευμένες γνώσεις του και για ακόμη μία φορά, ακούγεται να ζητεί από τον ασθενή να σταματήσει τη φαρμακευτική του αγωγή και να ακολουθήσει πιστά τις δικές του οδηγίες.
«Λογικά, θα έπρεπε να έχεις έναν αιματοκρίτη γύρω στο 30. Αλλά λόγω όλων αυτών που έχεις κάνει, έχεις 41. Καρκινοπαθής, με αιματοκρίτη 41, αιμοσφαιρίνη κάπου στο 14, αιμοπετάλια είχε περίπου 270, 280 χιλιάδες, οι εξετάσεις θα είναι εντελώς κάτω! Θα πέσεις στην μισή δοσολογία», ακούγεται να λέει δίνοντας στη συνέχεια γραπτές οδηγίες για το πώς ο… ασθενής, θα λαμβάνει σε σταγόνες τα σκευάσματα με τα βότανα.
Δείτε το βίντεο από το Mega: